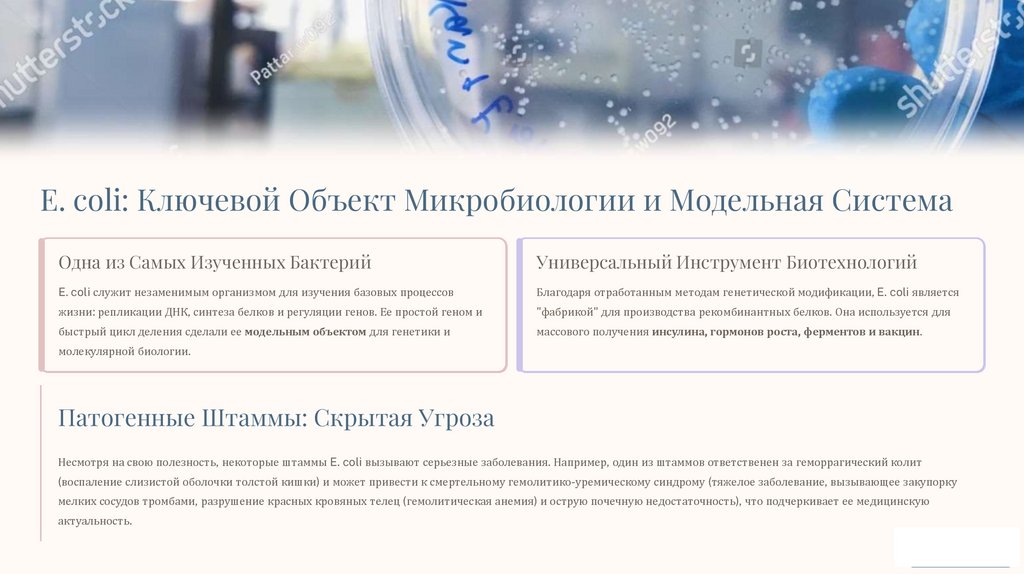

Similar presentations:
Почему объектом исследования выбрана Escherichia coli?
1.
Почему объектом исследованиявыбрана Escherichia coli?
Кишечная палочка, или E. coli, — не просто распространенная бактерия. Это
краеугольный камень современной биологии и медицины, предоставляющий
уникальные возможности для глубоких исследований.
Идеальная Модель
Инструмент Биотехнологий
Фундаментальная генетика и
Производство инсулина, вакцин,
физиология.
белков.
Клиническая Значимость
От кишечных инфекций до госпитальных штаммов.
2.
E. coli: Ключевой Объект Микробиологии и Модельная СистемаОдна из Самых Изученных Бактерий
Универсальный Инструмент Биотехнологий
E. coli служит незаменимым организмом для изучения базовых процессов
Благодаря отработанным методам генетической модификации, E. coli является
жизни: репликации ДНК, синтеза белков и регуляции генов. Ее простой геном и
"фабрикой" для производства рекомбинантных белков. Она используется для
быстрый цикл деления сделали ее модельным объектом для генетики и
массового получения инсулина, гормонов роста, ферментов и вакцин.
молекулярной биологии.
Патогенные Штаммы: Скрытая Угроза
Несмотря на свою полезность, некоторые штаммы E. coli вызывают серьезные заболевания. Например, один из штаммов ответственен за геморрагический колит
(воспаление слизистой оболочки толстой кишки) и может привести к смертельному гемолитико-уремическому синдрому (тяжелое заболевание, вызывающее закупорку
мелких сосудов тромбами, разрушение красных кровяных телец (гемолитическая анемия) и острую почечную недостаточность), что подчеркивает ее медицинскую
актуальность.
3.
Актуальность Исследования E. coli: Глобальная Угроза РезистентностиУсиление Антибиотикорезистентности
Исследование E. coli сегодня критически важно из-за мирового кризиса устойчивости к антибиотикам. Это один из
наиболее частых возбудителей, демонстрирующих высокий уровень устойчивости к препаратам первой линии:
90%
Устойчивость к Ампициллину
Доля штаммов E. coli, устойчивых к распространенному антибиотику .
75%
Мультирезистентность
Растущее число штаммов, устойчивых к трем и более классам антибиотиков.
Обнаружение мультирезистентных штаммов в продуктах питания и у людей (например, в Нигерии, 2025) требует немедленного научного ответа.
Понимание Механизмов
Исследование генетических путей, которые позволяют бактериям развивать
устойчивость.
Разработка Новых Стратегий
Поиск альтернативных методов лечения, таких как фаговая терапия или новые
Контроль Инфекций
Создание быстрых и точных систем обнаружения патогенных штаммов для
предотвращения вспышек.

biology
biology








